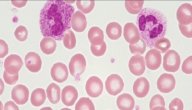

محتويات
كريات الدم البيضاء
تعد خلايا الدم البيضاء إحدى مكونات الدم الرئيسية، ويكون عددها عند الشخص السليم ما بين 4000 إلى 11000 خليةً في كل مايكروليتر من الدم، ولكن قد يزداد عددها عند مهاجمة الميكروبات والجراثيم للجسم، وتختلف خصائص كريات الدم البيضاء مثل الحجم والموصلية والحبوبية اعتماداً على التفعيل أو نتيجة وجود خلايا غير ناضجة أو خبيثة، ويعتبر عمر الكريات البيضاء قصيراً إذا ما قورن بغيرها من الخلايا حيث لا يتجاوز عمرها عدة ساعات في الخلايا الليمفاوية، ومن يوم إلى يومين في الخلايا الأخرى.
وظيفة كريات الدم البيضاء
- حماية الجسم ووقايته من الإصابة بالميكروبات والجراثيم التي تسبب الأمراض المختلفة، ويكون ذلك من خلال التهامها أو تحليلها، وينتج عن ذلك موت بعضاً من خلايا الدم البيضاء لينتج بما يسمى بالخلايا الصديدية.
- تحسين الأوعية الدموية نتيجة إفراز الخلايا الحامضية (الأزينوفيل) لمادة الهسامين التي تساعد في توسيع الأوعية الدموية.
- وقاية الجسم من الإصابة بتجلط الدم بسبب احتوائها مادة الهيبارين.
- معالجة الجروح التي تصيب الجسم، والمساهمة في سرعة التئامها ووقايتها من الإصابة بالبكتيريا لاحتوائها على مادة المونوسايت.
- المحافظة على صحة الغدة الدرقية وحماية الجسم من الأمراض التي تنتج من اضطرابها.
- تحليل الدهون المتراكمة في الجسم.
- التخلص من السموم في الجسم نتيجة لإفراز الخلايا الليمفاوية للأجسام المضادة التي تعادل سموم الميكروبات.
أنواع كريات الدم البيضاء
- الفئات المحببة: يتم إنتاج هذه الفئات في نخاع العظم الأحمر، حيث تكون على شكل أنزيمات مرتبطةً بالغشاء وتحتوي على حبيبات في الهيولى، وتنقسم إلى خلايا حمضية، وخلايا قاعدية، وخلايا متعادلة، ووظيفتها هضم الأجسام التي تقوم الكريات بابتلاعها.
- الفئات غير المحببة: يتم إنتاج هذه الفئات في الأنسجة الليمفاوية كالغدد الليمفاوية، والطحال، والكبد، وتختلف عن الفئات المحببة بغياب الحبيبات في الهيولى، وتنقسم إلى وحيدات النوى، والبلاعم، والليمفاويات.
أسباب ارتفاع كريات الدم البيضاء
تتعدد الأسباب التي قد تؤدي إلى ارتفاع عدد كريات الدم البيضاء، ومنها:
- الإصابة بالسرطان وخاصةً سرطان الدم.
- الإصابة بأنواع الالتهابات المختلفة مثل التهاب المفاصل.
- تناول بعض الأنواع من الأدوية التي لها آثار جانبية تؤدي إلى ارتفاع عدد الكريات مثل أدوية السرطان وأدوية التهاب المفاصل.
- الإدمان على التدخين.
- الإصابة بمرض نقص المناعة المكتسبة، وأمراض الجهاز التنفسي.
- الحمل.
- الإصابة بالنزيف الشديد، أو تلف في الأنسجة.
أعراض ارتفاع كريات الدم البيضاء
تظهر أعراض ارتفاع عدد كريات الدم البيضاء على شكل:
- الإصابة بالتعب والإرهاق بشكلٍ كبيرٍ.
- الإصابة بآلامٍ في أنحاء الجسم المختلفة وخاصةً القدمين واليدين.
- التشوش الذهني.
- انخفاض الوزن بصورةٍ مفاجئةٍ.
- الدوار والدخول في الغيبوبة عند تقدم الإصابة.
المراجع: 1

.jpg)


